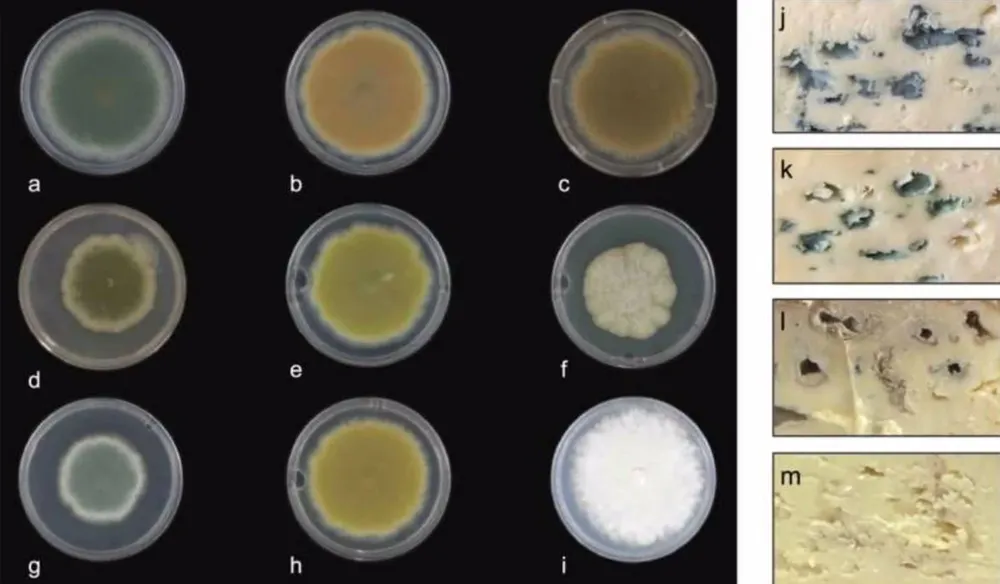
El queso azul ya puede producirse con otros colores.

Expertos de la Universidad de Nottingham han descubierto cómo crear queso azul de diferentes colores mediante la variación del pigmento que generan los hongos responsables de su maduración.
Después de descubrir cómo se crea la clásica veta azul verdosa, un equipo de expertos de la Facultad de Ciencias de la Vida pudo crear una variedad de cepas de hongos diferentes que podrían usarse para hacer queso con colores que van desde el blanco hasta el amarillo verdoso y rojo-marrón-rosa y azules claros y oscuros.
Los hallazgos del estudio se publican en la revista Science of Food.
El hongo Penicillium roqueforti se utiliza mundialmente en la producción de quesos de veta azul como el Stilton, Roquefort y Gorgonzola. Su color y sabor únicos, azul verdoso, provienen de esporas pigmentadas formadas por el crecimiento de hongos. Utilizando una combinación de bioinformática, deleciones genéticas específicas y expresión de genes
heterólogos, el equipo de investigación, dirigido por el Dr. Paul Dyer, profesor de biología fúngica, aprendió la forma en que se produce el pigmento azul verdoso.
Los investigadores descubrieron que una vía bioquímica forma gradualmente los pigmentos azules, comenzando con un color blanco, que progresivamente se vuelve amarillo verdoso, rojo marrón rosado, marrón oscuro, azul claro y finalmente azul verdoso oscuro. Luego, el equipo pudo utilizar algunas técnicas clásicas seguras para los alimentos (no transgénicas) para "bloquear" el camino en ciertos puntos y así crear cepas con nuevos colores que pueden usarse en la producción de queso.
El Dr. Dyer dijo: "Hemos estado interesados en los hongos del queso durante más de 10 años y tradicionalmente, cuando se desarrollan quesos madurados con moho, se obtienen quesos azules como Stilton, Roquefort y Gorgonzola, que utilizan cepas fijas de hongos que son de color azul verdoso. Queríamos ver si podíamos desarrollar nuevas cepas con nuevos sabores y apariencias.
"La forma en que lo hicimos fue inducir la reproducción sexual en el hongo, por lo que por primera vez pudimos generar una amplia gama de cepas que tenían sabores novedosos, incluidos sabores nuevos y atractivos, suaves e intensos. Luego creamos nuevas versiones de colores de algunas de estas nuevas cepas."
Una vez que el equipo produjo el queso con las nuevas cepas de color, utilizaron instrumentos de diagnóstico de laboratorio para ver cómo sería el sabor.
"Descubrimos que el sabor era muy similar al de las cepas azules originales de las que se derivaron", dijo el Dr. Dyer. "Hubo diferencias sutiles pero no muchas. Lo interesante fue que una vez que hicimos algo de queso, hicimos algunas pruebas de sabor con voluntarios de toda la Universidad y descubrimos que cuando las personas probaban las variedades de colores más claros pensaban que sabían más suaves. Pensaron que la cepa más oscura tenía un sabor más intenso.
"Del mismo modo, con el marrón más rojizo y el verde claro, la gente pensó que tenían un elemento ácido y afrutado, mientras que según los instrumentos de laboratorio eran muy similares en sabor. Esto demuestra que las personas perciben el sabor no sólo por lo que gusto sino también por lo que ven."
El equipo, que incluía al estudiante de posgrado Matt Cleere, ahora buscará trabajar con queseros tanto en Nottinghamshire como en Escocia para crear las nuevas variantes de color del queso azul. También se ha creado una empresa derivada de la Universidad llamada Myconeos para ver si las cepas se pueden comercializar.
"Personalmente, creo que brindará a la gente una sensación sensorial realmente satisfactoria al comer estos nuevos quesos y, con suerte, podría atraer a algunas personas nuevas al mercado", añade el Dr. Dyer. EuropaPress.